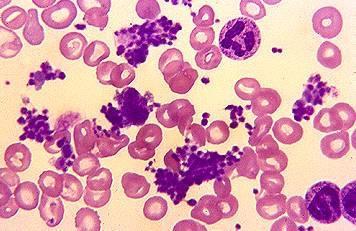
过敏性紫癜血小板数量增高,原因为何?

紫癜 血小板

血小板减少性紫癜有出血,神经系统异常,微血管病性溶血,肾功能损旱热
图片尺寸1355x1280
血栓性血小板减少性紫癜的症状和图片 - 有来医生
图片尺寸400x300
特发性血小板减少性紫癜
图片尺寸3024x4032
血小板增多性紫癜
图片尺寸750x563
儿童紫癜肾炎症状有哪些?_血小板
图片尺寸4032x3024
紫癜但血小板是正常的
图片尺寸533x400
同样是瘀斑,过敏性紫癜与特发性血小板减少性紫癜有何不同
图片尺寸429x319
特发性血小板减少性紫癜
图片尺寸220x187
真相却出乎意料|压力性紫癜|过敏性紫癜|血小板|特发性|吻痕|真相
图片尺寸449x351
小腿青紫莫忽视小心血栓性血小板减少性紫癜
图片尺寸720x486
特发性血小板减少性紫癜治疗经历-第一次住院
图片尺寸3024x3851
过敏性血小板减少性紫癜怀孕复发了 - 血小板低病友交流
图片尺寸464x519
特发性血小板减少性紫癜的护理
图片尺寸920x690
原发性血小板减少性紫癜治疗案例 梁某,30岁.2019年5月3日初诊.
图片尺寸1923x1280
特发性血小板减少性紫癜ppt
图片尺寸1080x810
血小板减少性紫癜|出血|症状_网易订阅
图片尺寸640x397
过敏性紫癜,血小板减少性紫癜,不用怕!
图片尺寸660x378
特发性血小板减少性紫癜ppt
图片尺寸1080x810
过敏性紫癜血小板数量增高,原因为何?
图片尺寸356x231
特发性血小板减少性紫癜患者的护理课件_第5页
图片尺寸920x661